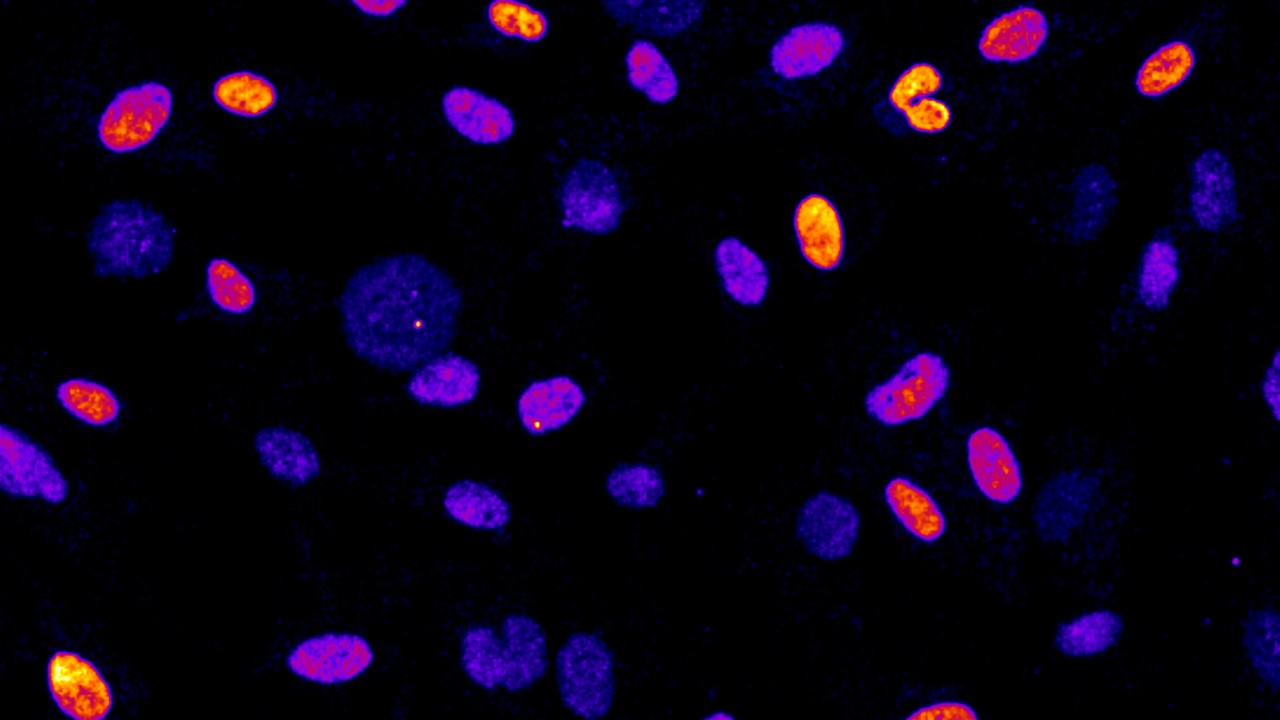

新入荷
再入荷
送料無料 いくらから 四国化成 建材サーチ | GTF3型(アルミカラー)【2023年版】 | 社会学
 タイムセール
タイムセール
終了まで
00
00
00
999円以上お買上げで送料無料(※)
999円以上お買上げで代引き手数料無料
999円以上お買上げで代引き手数料無料
通販と店舗では販売価格や税表示が異なる場合がございます。また店頭ではすでに品切れの場合もございます。予めご了承ください。
商品詳細情報
| 管理番号 |
新品 :30168235531
中古 :30168235531-1 |
メーカー | 7dd3dba781a | 発売日 | 2025-06-07 16:49 | 定価 | 4291円 | ||
|---|---|---|---|---|---|---|---|---|---|
| カテゴリ | |||||||||
送料無料 いくらから 四国化成 建材サーチ | GTF3型(アルミカラー)【2023年版】 | 社会学
 四国化成 | GTF3型(アルミカラー)【2023年版】 | 建材サーチ,
四国化成 | GTF3型(アルミカラー)【2023年版】 | 建材サーチ, 中国科大揭示非均质结构中三维扭曲裂纹的形成与增韧机制,
中国科大揭示非均质结构中三维扭曲裂纹的形成与增韧机制, 染色体上で二本鎖DNA切断を修復する仕組みを解明――DNA の二本鎖,
染色体上で二本鎖DNA切断を修復する仕組みを解明――DNA の二本鎖, オリジナル・モデルの精神を継承しつつ高い品位を追求した“KSK,
オリジナル・モデルの精神を継承しつつ高い品位を追求した“KSK, 細胞分裂時の異常を細胞が検出する分子メカニズムを発見 | 沖縄
細胞分裂時の異常を細胞が検出する分子メカニズムを発見 | 沖縄昭和35年 石川 忠雄 (翻訳) 日本外政学会 天地小口、ページにヤケ。沖縄の米軍基地 平成10年3月。カバーにヤケ、やぶれ、スレ、キズはありますが、中身状態は経年並です。わが県の改造計画プラン集―日本列島はこう変わる 都道府県別。





















![[古本]サンダーバード大百科 GakkenMOOK *ポスター付](https://auctions.c.yimg.jp/images.auctions.yahoo.co.jp/image/dr502/auc0303/users/e3b0c44298fc1c149afbf4c8996fb92427ae41e4649b934ca495991b7852b855/i-img494x600-13964361989ieqtm2601.jpg)
![【中古】 学校の怖い噂 1~最新巻 (講談社コミックス ) [コミックセット]](https://auctions.c.yimg.jp/images.auctions.yahoo.co.jp/image/dr000/auc0411/users/a2c475b24c35ded09e75e1acd941de7041790bcb/i-img500x500-1700907736icmuj21165274.jpg)




